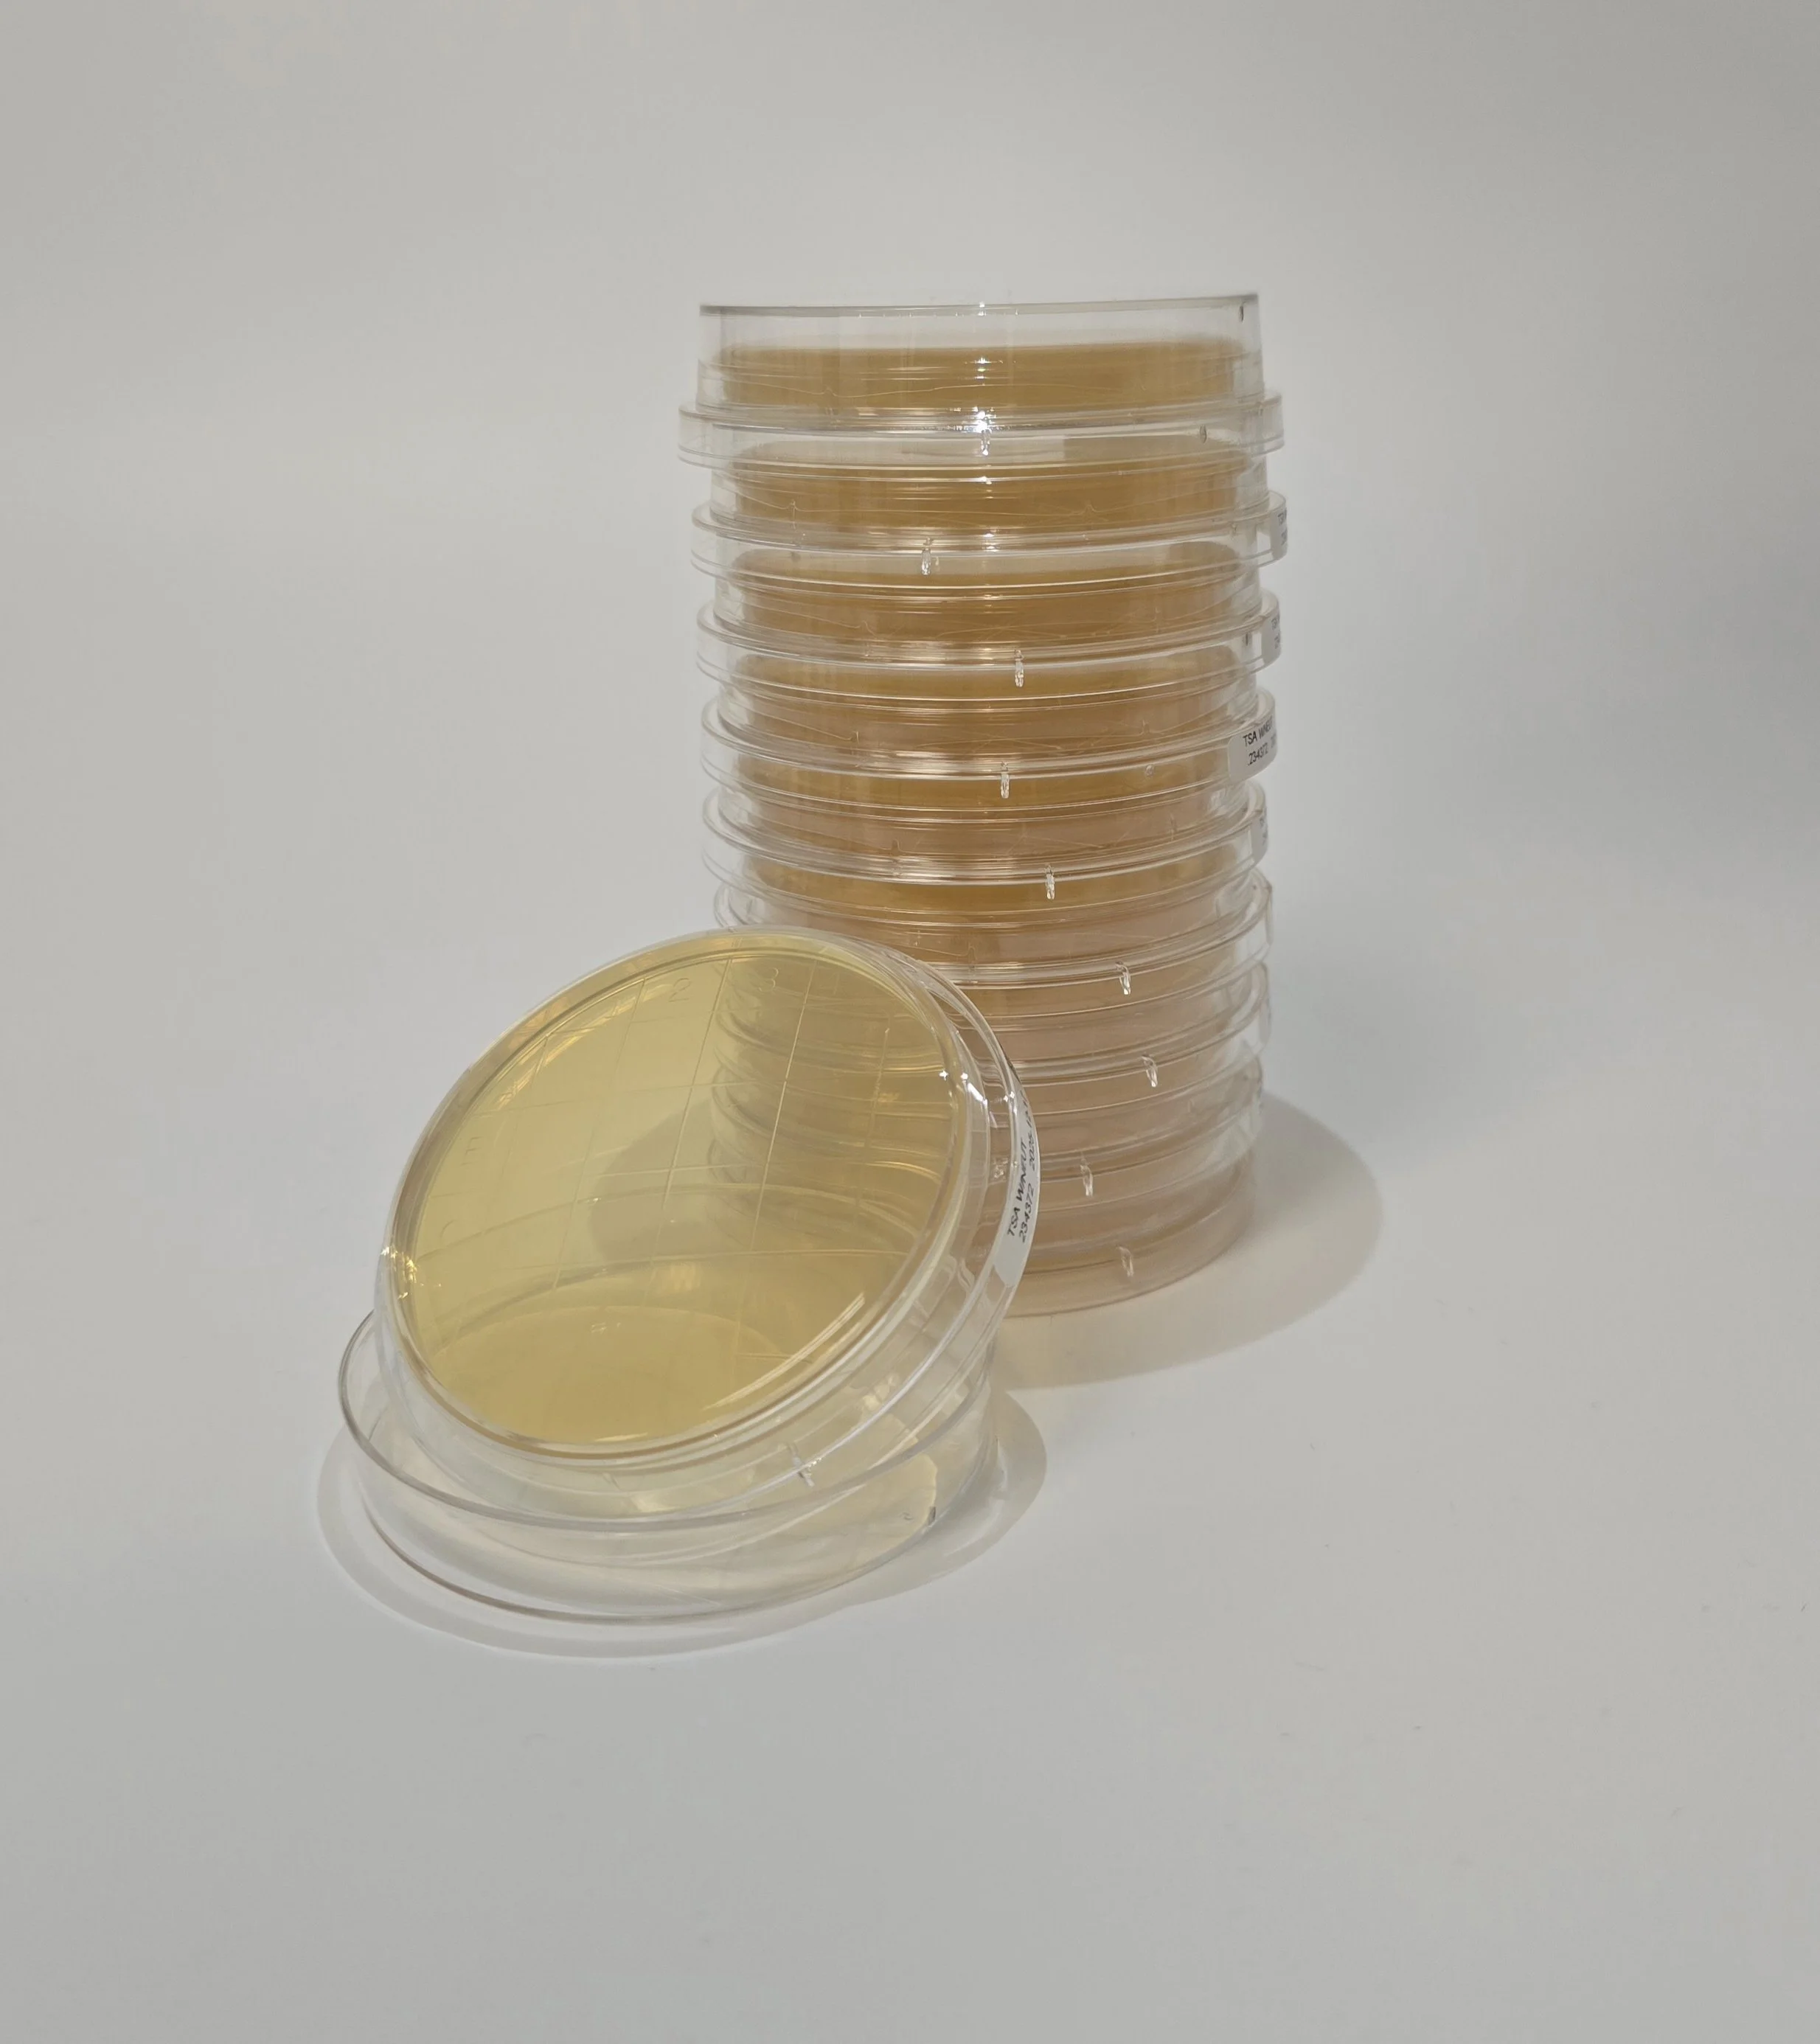

Store
TSA (Tryptic Soy Agar) Contact Plates - Triple Wrapped - 10 Pack
$40.00
- Sterile (Irradiated)
- Used for surface or personnel sampling
Three protective layers reduce risk of contamination:
Primary film with moisture control patch
Secondary film VHP barrier with immobilized desiccant sachet
Tertiary film dust cover
Quantity: